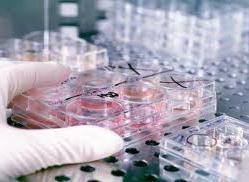

รับผลิตเครื่องสำอางสกินแคร์ออแกนิค สารสกัดธรรมชาติ ผัก ผลไม้ 100% & ดำเนินการขอ อย. แบรนด์สินค้า-ลิขสิทธิ์ของลูกค้า สร้างแบรนด์ ครบวงจร ราคาเริ่มต้นที่ 300 บาท
รับผลิตสกินแคร์ออแกนิค สารสกัดธรรมชาติ ผัก ผลไม้ 100% & ดำเนินการขอ อย. แบรนด์สินค้า-ลิขสิทธิ์ของลูกค้า สร้างแบรนด์ ครบวงจร เริ่มที่ 300 บาท ( สิขสิทธิ์ สูตรสินค้า เป็นของลูกค้า 100% เลขที่ อย. ไม่ซ้ำลูกค้าท่านอื่นแน่นอน พร้อมรับดำเนินการวิ่งเอกสาร เปิดบริษัท พร้อมรับรอง-ดำเนินการเอกสารกับหน่วยงานของ อย. อำนวยความสะดวกและประหยัดเวลาดำเนินการทางด้านเอกสารให้ลูกค้า เพื่อให้ลูกค้ามีสิทธิในการถือครองความเปนเจ้าของสินค้าแต่เพียงผู้เดียวอย่างง่ายโดยที่ท่านไม่ต้องทำอะไรเลย สนใจสอบถามเพิ่มเติมรายละเอียดได้ค่ะ )
http://www.orichy.com
------------------------------------------------------------------
Orichy interbusiness partnership & Other company by OIB
โอริชชี่ รับผลิตสินค้า พร้อมการดำเนินการขึ้นทะเบียน อย. อย่างถูกต้อง ด้วยระบบการผลิตและเครื่องมือที่ได้มาตราฐานการผลิตโดยแลปบอราทอรี่ของเราเอง
ทุกขั้นตอนผ่านกรรมวิธีและกระบวนการผลิตโดยผู้เชี่ยวชาญและมีประสบการณ์จริงทางด้านการศึกษาค้นคว้าวิจัยและทดลองในห้องแลปวิทยาศาสตร์มากกว่า 5 ปี เชี่ยวชาญในการในเครื่องมือ ตลอดจนเทคนิคและหลักการทางวิทยาศาสตร์ การันตีมาตราฐานและประสบการณ์ด้วย...วุฒิการศึกษาวิทยาศาสตร์บัญฑิต ซึ่งเป็นผู้ควบคุมดูแลการผลิตสินค้าแบรนด์ของเราและสินค้าในเครือโอริชชี่กว่า 500 ชนิด
เราเน้นคุณภาพจากวิถีบำบัดธรรมชาติ ใส่ใจในทุกรายละเอียด เราเน้นคุณภาพและใส่ใจประสิทธิภาพของผลงานทุกชนิดจากแลปของเราเหนือสิ่งอื่นใด โดยไม่มุ่งเน้นผลกำไรจากลูกค้า เพราะเราใช้หลักการดำเนินธุรกิจแบบสามัญ ไม่มุ่งเน้นผลกำไร และมุ่งเน้นถึงรอยยิ้มและความพึงพอใจของลูกค้าด้วยแนวทางและสโลแกน " เพราะมีคุณ...จึงมีเราในวันนี้ "
ผลิตสินค้าโดยเน้นสารสกัดออร์แกนิคและไบโอเนเจอรัลจากธรรมชาติ จากพืช-ผล-ดอกไม้ที่ปราศจากสารพิษจากสวนและไร่ของเราเอง ด้วยความพยายามที่จะพัฒนาค้นคว้าวิจัยสารสกัดจากธรรมชาติ เพื่อให้ลูกค้าของเราได้ใช้สินค้าที่เป็นธรรมชาติอย่างแท้จริง อาทิ ปลูกพืชไฮรโดรโปรนิค ปลูกด้วยน้ำ โดยไม่ใส่ปุ๋ยเคมี ปราศจากสารตกค้าง ตลอดจนการคัดสรรจากสารสกัดที่เราเลือกสิ่งที่ดีที่สุดจากทั่วทุกมุมโลก อาทิ พืช ผัก ผลไม้เมืองหนาว โดยเปนสารสกัด 100% มีความเข้มข้นวิตามินและประสิทธิภาพดีต่อผิวหนัง โดยเราคัดสรรเฉพาะสารสกัดที่มีคุณภาพมาตราฐานผ่านการตรวจสอบและมีความปลอดภัยและเข้มข้นสูง 100% ปราศจากสารต้องห้าม โดยนำมาผลิตด้วยเครื่องมือที่สะอาดปลอดภัยได้มาตราฐาน
สำหรับผู้เริ่มธุรกิจใหม่...คุณเองก็เป็นเจ้าของธุรกิจได้ง่ายๆ เพียงสั่งซื้อสินค้าของเราขั้นต่ำ 100 กรัม ( 1 ขีด ) ทางเราพร้อมอำนวยความสะดวกในการดำเนินการทะเบียน อย. ภายใต้แบรนด์ และ ในส่วนความเป็นเจ้าของสินค้าให้เป็นของท่านเองง่ายๆ ลงทุนเพียงหลักร้อยก็สามารถมีแบรนด์และเลขที่ อย. เป็นชื่อของท่าน ( เป็นเจ้าของกิจการโดยสมบูรณ์ ได้รับเอกสารรับรองถูกต้องตามกฎหมาย สามารถจำหน่ายได้อย่างถูกต้องภายในและภายนอกประเทศ ^^ )เริ่มต้นที่ 500 บาท สนใจสอบถามเพิ่มเติมได้ที่ 080-221-6888
สำหรับนักธุรกิจทุกท่านที่ดำเนินกิจการจำหน่ายผลิตภัณฑ์สินค้าด้านความงาม ผู้ที่สั่งผลิตสินค้ากับแลปของเรา จำนวนที่กำหนด ขั้นต่ำที่ 1 กิโลกรัม ทางเราพร้อมดำเนินการขึ้นเลขทะเบียน อย. ให้ฟรี ในกรณีที่สั่งผลิตสินค้าไม่ถึงจำนวนที่เรากำหนดไว้ ทางเราคิดค่าดำเนินการแบบกันเอง เริ่มต้นที่ 300 บาท สนใจสอบถามเพิ่มเติมได้ที่ 080-221-6888
* รับผลิตสินค้าตามไอเดียทุกออร์เดอร์ รับออกแบบเนื้อครีมผลิตภัณฑ์ที่ได้มาตราฐานฟรี รับผลิตครีมตามตัวอย่างเดิม...ในราคาที่ประหยัดกว่า SAVE COST กว่าตัวอย่างเดิม 30-80 % มั่นใจได้กว่าคุณจะจ่ายน้อยกว่าได้แต่สารอาหารและคุณภาพที่มากกว่า ด้านความถนัดในการปรับปรุงคุณภาพต้องยกให้เรา เพราะเราคือผู้ผลิตสกินแคร์บำรุงผิวหน้าที่เลือกสรรค์สารสกัดธรรมชาติ 100 % *** เริ่มต้นราคา สกินแคร์บำรุงผิวหน้าทรงประสิทธิภาพใส่สารสกัดธรรมชาติ 100% มากกว่า 10 ชนิด เริ่มต้นราคาที่กิโลกรัมละ 1,500 บาท เท่านั้น สนใจสอบถามเพิ่มเติมได้ที่ 080-221-6888
![]() |
| ราคา: | ไม่ระบุ | ต้องการ: | ขาย/ให้เช่า/แลก | ||
| ติดต่อ: | DR.MV LAB CO.LTD and OIB PARTNERSHIP | อีเมล์: | |||
| สภาพ: | ใหม่ | จังหวัด: | กรุงเทพมหานคร | ||
| โทรศัพย์: | 0802216888 | IP Address: | 115.87.209.11 | ||